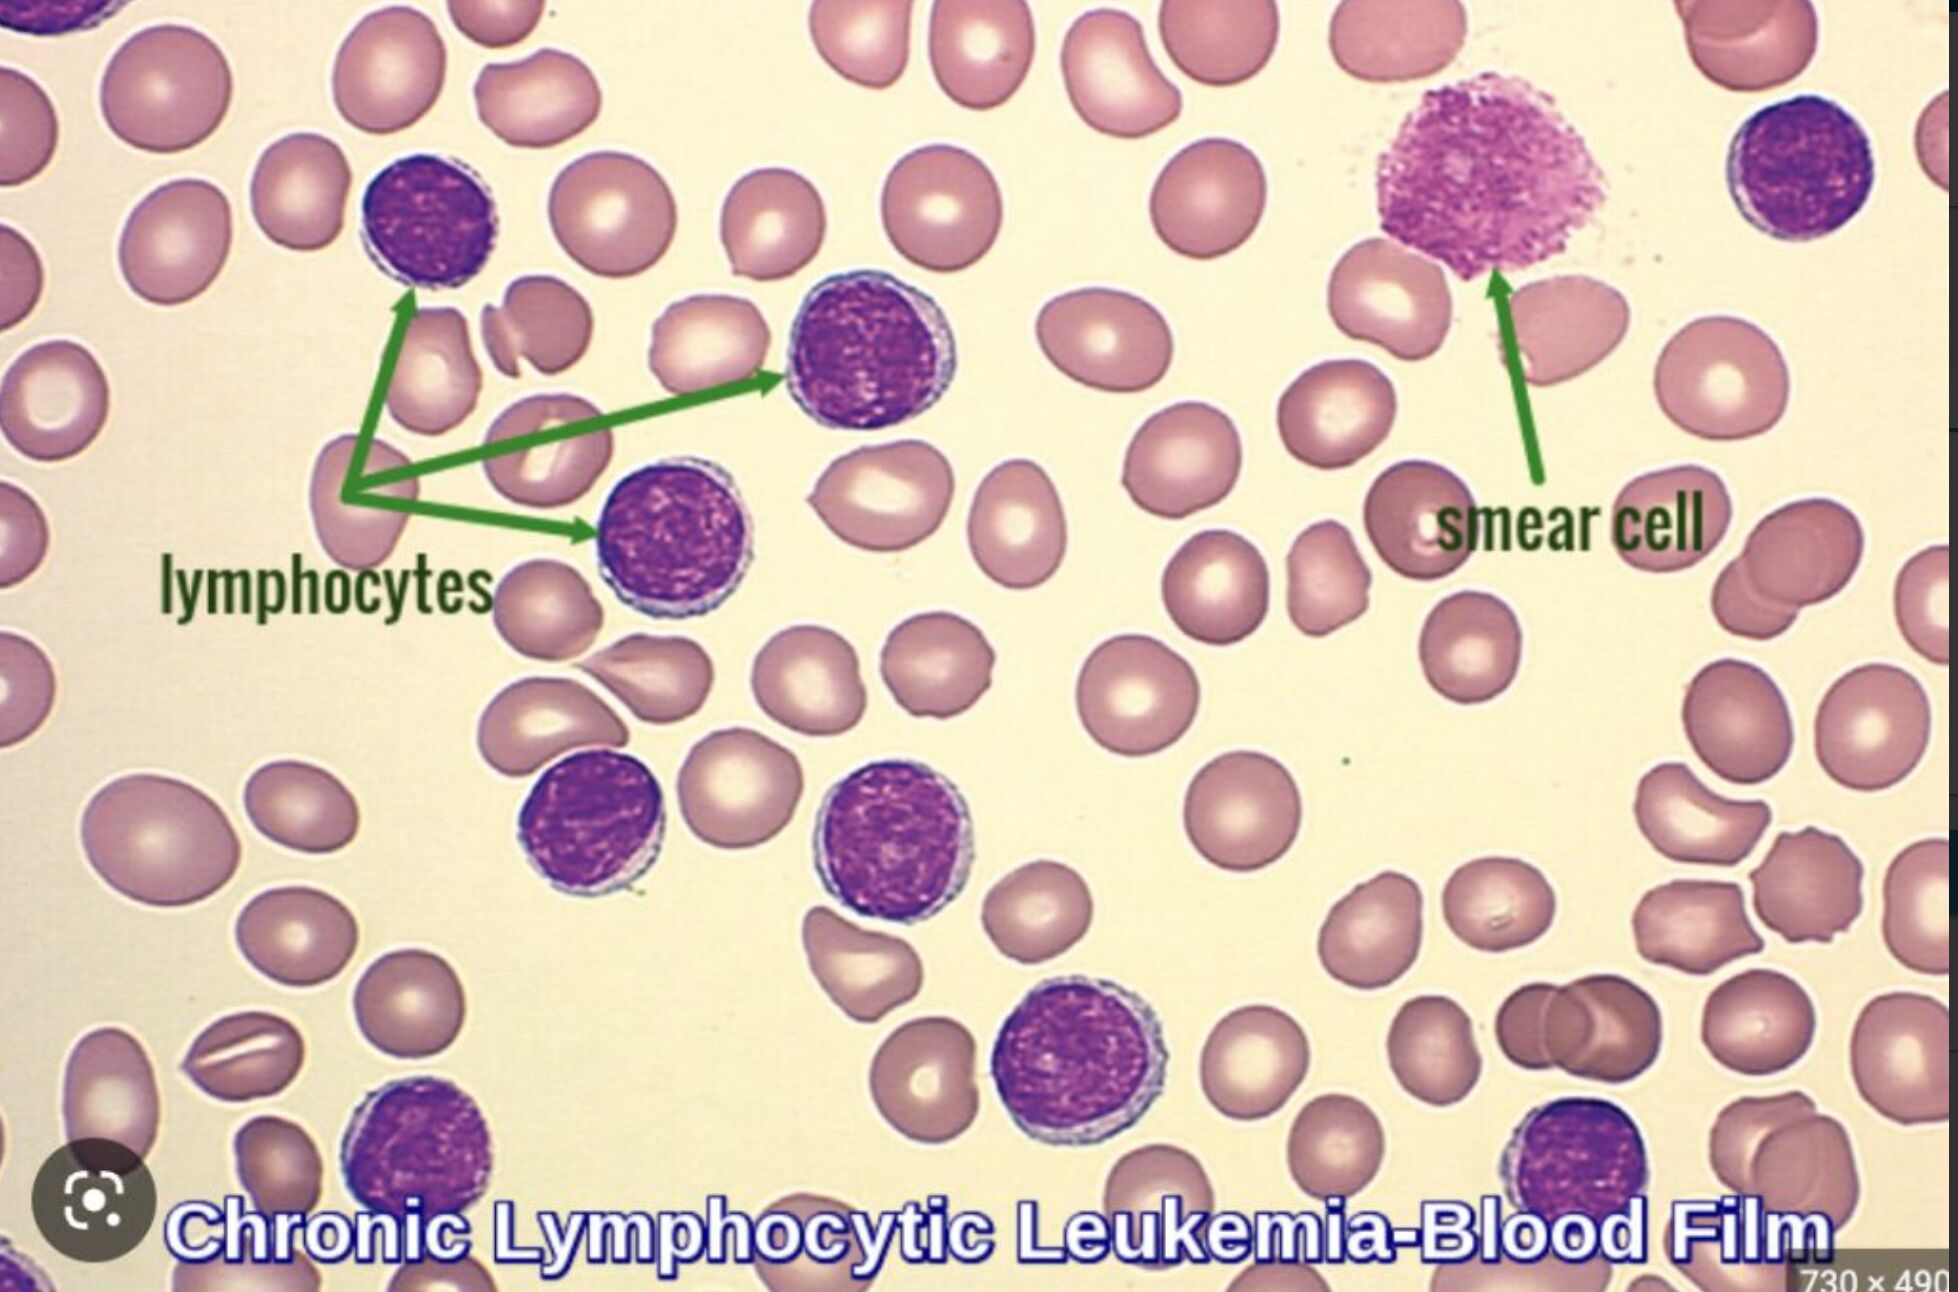
686c9f975b04c.jpg
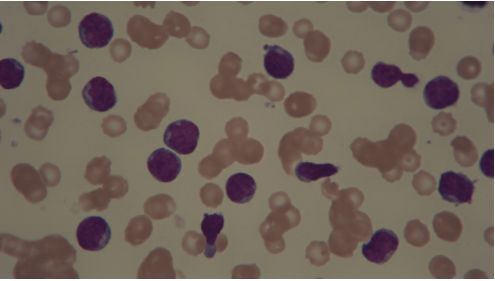
686c9f93904ac.jpg
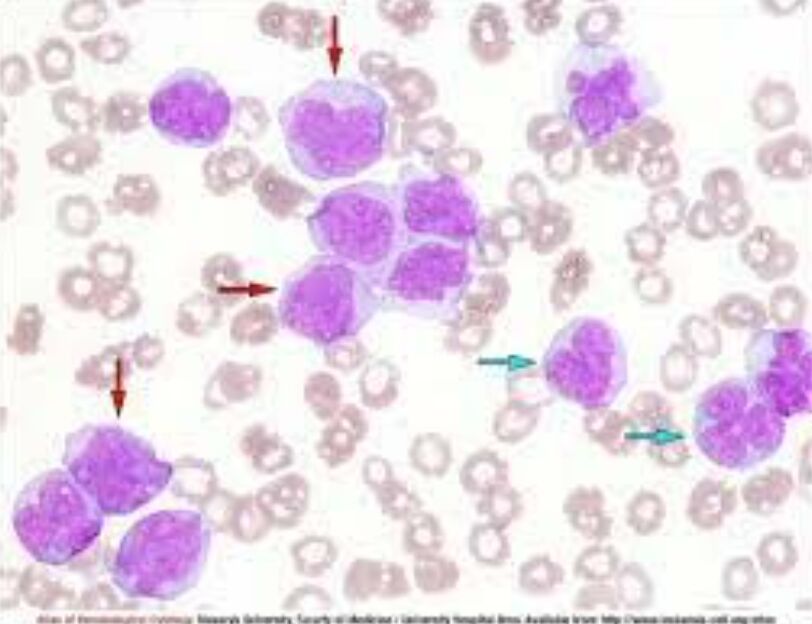
686c9f94a61b8.jpg
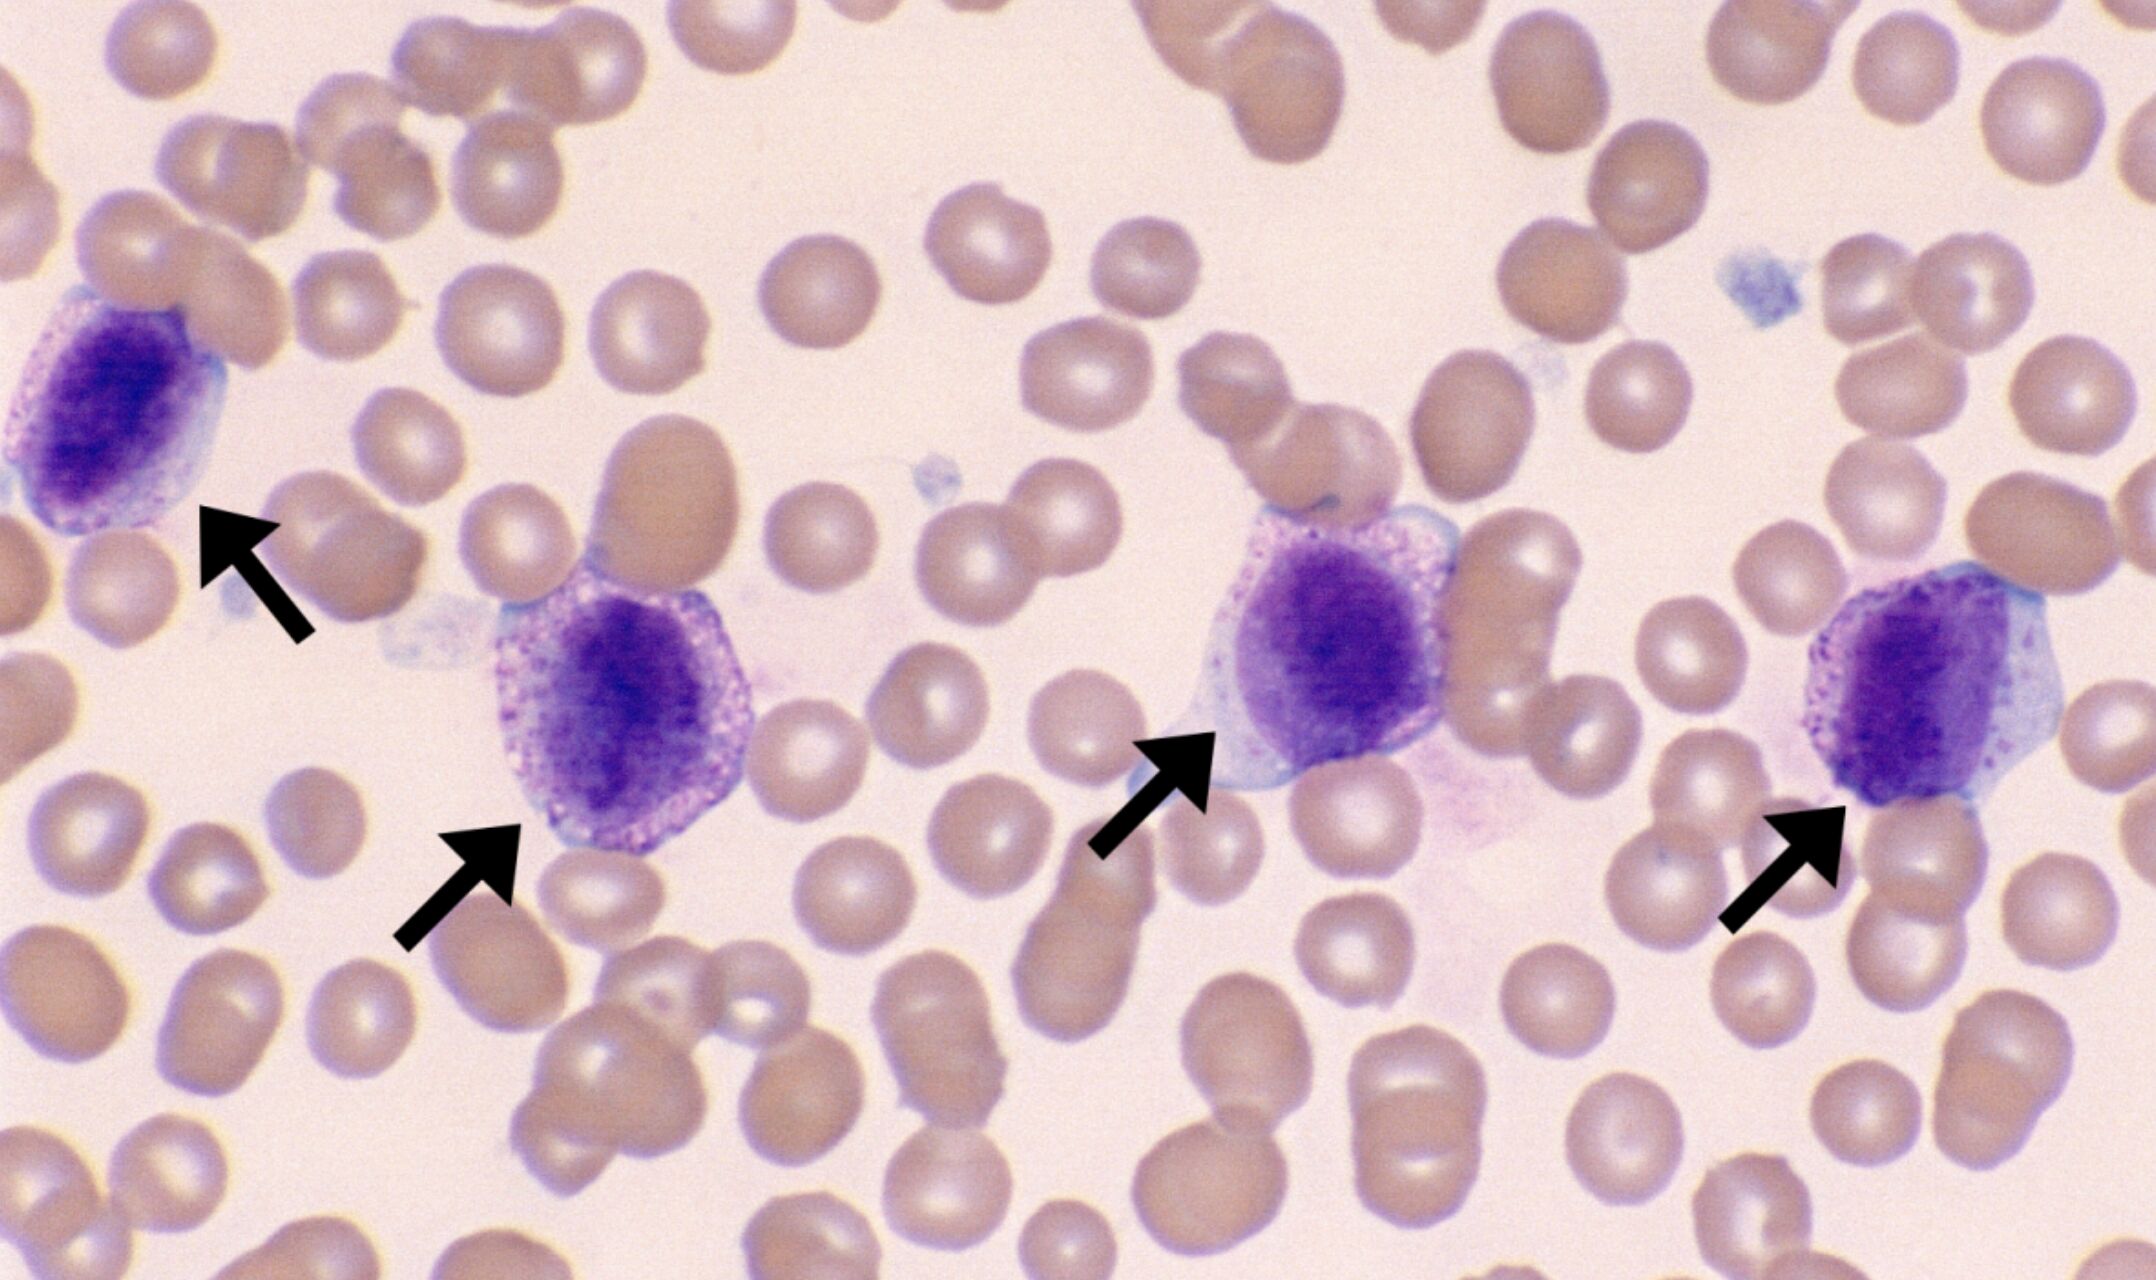
686c9f98c8484.jpg

27.下圖為犬隻白血病血液抹片,可推測最可能罹患何種疾病?
(A)lymphoid leukemia
(B)monocytic leukemia
(C)plasma cell myeloma
(D)basophilic leukemia

(A)lymphoid leukemia
(B)monocytic leukemia
(C)plasma cell myeloma
(D)basophilic leukemia
答案:登入後查看
統計: A(2091), B(665), C(267), D(56), E(0) #2182441
統計: A(2091), B(665), C(267), D(56), E(0) #2182441
詳解 (共 4 筆)
#6527407
Leukemia cytology
lymphoid leukemia
27.下圖為犬隻白血病血液抹片,可推測最可能罹患何種疾病? lymphoid leukemia
Monocytic leukemia(比RBC大很多)
Mast cell leukemia
Basophilic leukemia

2
0
#5717757
lymphoid leukemia
0
1